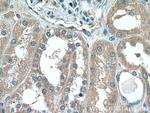
ABP1 Antibody in Immunohistochemistry (Paraffin) (IHC (P))
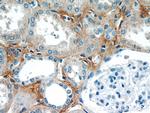
ABP1 Antibody in Immunohistochemistry (Paraffin) (IHC (P))

Search
Proteintech
ABP1 Polyclonal Antibody
{{$productOrderCtrl.translations['antibody.pdp.commerceCard.promotion.promotions']}}
{{$productOrderCtrl.translations['antibody.pdp.commerceCard.promotion.viewpromo']}}
{{$productOrderCtrl.translations['antibody.pdp.commerceCard.promotion.promocode']}}: {{promo.promoCode}} {{promo.promoTitle}} {{promo.promoDescription}}. {{$productOrderCtrl.translations['antibody.pdp.commerceCard.promotion.learnmore']}}
产品信息
16338-1-AP
种属反应
宿主/亚型
分类
类型
抗原
偶联物
形式
浓度
规格
纯化类型
保存液
内含物
保存条件
运输条件
产品详细信息
Immunogen sequence: TFHYYDADD PVHYPRALCL FEMPTGVPLR RHFNSNFKGG FNFYAGLKGQ VLVLRTTSTV YNYDYIWDFI FYPNGVMEAK MHATGYVHAT FYTPEGLRHG TRLHTHLIGN IHTHLVHYRV DLDVAGTKNS FQTLQMKLEN ITNPWSPRHR VVQPTLEQTQ YSWERQAAFR FKRKLPKYLL FTSPQENPWG HKRSYRLQIH SMADQVLPPG WQEEQAITWA RYPLAVTKYR ESELCSSSIY HQNDPWDPPV VFEQFLHNNE NIENEDLVAW VTVGFLHIPH SEDIPNTATP GNSVGFLLRP FNFFPEDPSL ASRDTVIVWP RDNGPNYVQR WIPEDRDCSM PPPFSYNGTY RPV (400-751 aa encoded by BC014093)
靶标信息
This gene encodes a metal-binding membrane glycoprotein that oxidatively deaminates putrescine, histamine, and related compounds. The encoded protein is inhibited by amiloride, a diuretic that acts by closing epithelial sodium ion channels. Alternatively spliced transcript variants encoding multiple isoforms have been observed for this gene.
仅用于科研。不用于诊断过程。未经明确授权不得转售。
生物信息学
蛋白别名: amiloride binding protein 1 (amine oxidase (copper-containing)); Amiloride-binding protein; Amiloride-binding protein 1; amiloride-sensitive amine oxidase; Amine oxidase copper domain-containing protein 1; Diamine oxidase; Diamine oxidase [copper-containing]; Histaminase; KAO; Kidney amine oxidase; unnamed protein product
基因别名: ABP; ABP1; AOC1; DAO; DAO1; KAO; KDAO
UniProt ID: (Human) P19801
Entrez Gene ID: (Human) 26